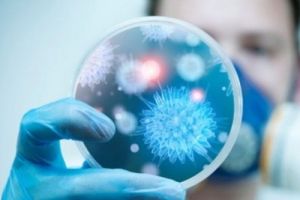

قالت مصادر المعارضة السورية اليوم الإثنين (19 مايو / أيار 2014) ان وزير الدفاع في حكومة المعارضة استقال بعد خلافات مع رئيس الائتلاف الوطني السوري المعارض وهو ما أبرز الانقسامات الجارية بين القوى التي تحاول الاطاحة بالرئيس السوري بشار الاسد.
وعين أسعد مصطفى الذي تدعمه السعودية في منصب وزير الدفاع في نوفمبر تشرين الثاني في اطار خطة للائتلاف الوطني السوري لادارة المناطق التي سيطرت عليها قوات المعارضة في البلاد التي تمزقها حرب أهلية.
لكن حكومة المعارضة في المنفى لم تتمكن من السيطرة على جماعات المعارضة المتناحرة ومنها جماعات تابعة لتنظيم القاعدة ولم تلق سوى مساعدات هامشية من داعميها الغربيين.
وعمل مصطفى وهو في الستينيات وزيرا للزراعة في حكومة والد بشار الرئيس السوري الراحل حافظ الاسد لكنه انشق بعد اندلاع الانتفاضة المناهضة لحكم أسرة الاسد الممتد منذ 40 عاما في مارس آذار عام 2011 والتي تحولت الى حرب أهلية.
وقال مصدر من المعارضة مقرب من وزير الدفاع انه استقال الليلة الماضية احتجاجا على نقص الأموال المقدمة الى مقاتليه من أحمد الجربا رئيس الائتلاف الوطني.
لكن مصدرا في الائتلاف قال ان مصطفى استقال بعد ان رفض الجربا تعيينه رئيس وزراء مؤقتا وهو منصب يشغله الان أحمد طعمة الاسلامي المعتدل.
وقال المصدر الذي طلب عدم الكشف عن هويته ان مصطفى "لم يحقق شيئا. فقدنا سوريا. فقدناها للجهاديين وللأسد."
ولم يتسن لرويترز الاتصال بمصطفى للتعليق.
وسيظل الجربا رئيسا للائتلاف الوطني السوري المعارض حتى يونيو حزيران حين يتم انتخاب رئيس جديد او تمدد رئاسته.

للفلوس فقط
استقال لأن دول الخليج وقفت شوي تحويل الفلوس له ، وبعدين أهو ريش من فلوس الخليج بعد ما فيه داعي يستمر في الهرار والخريط . الحين بروح باريس ببسط ويرتاح وخلهم تاكلهم النار .